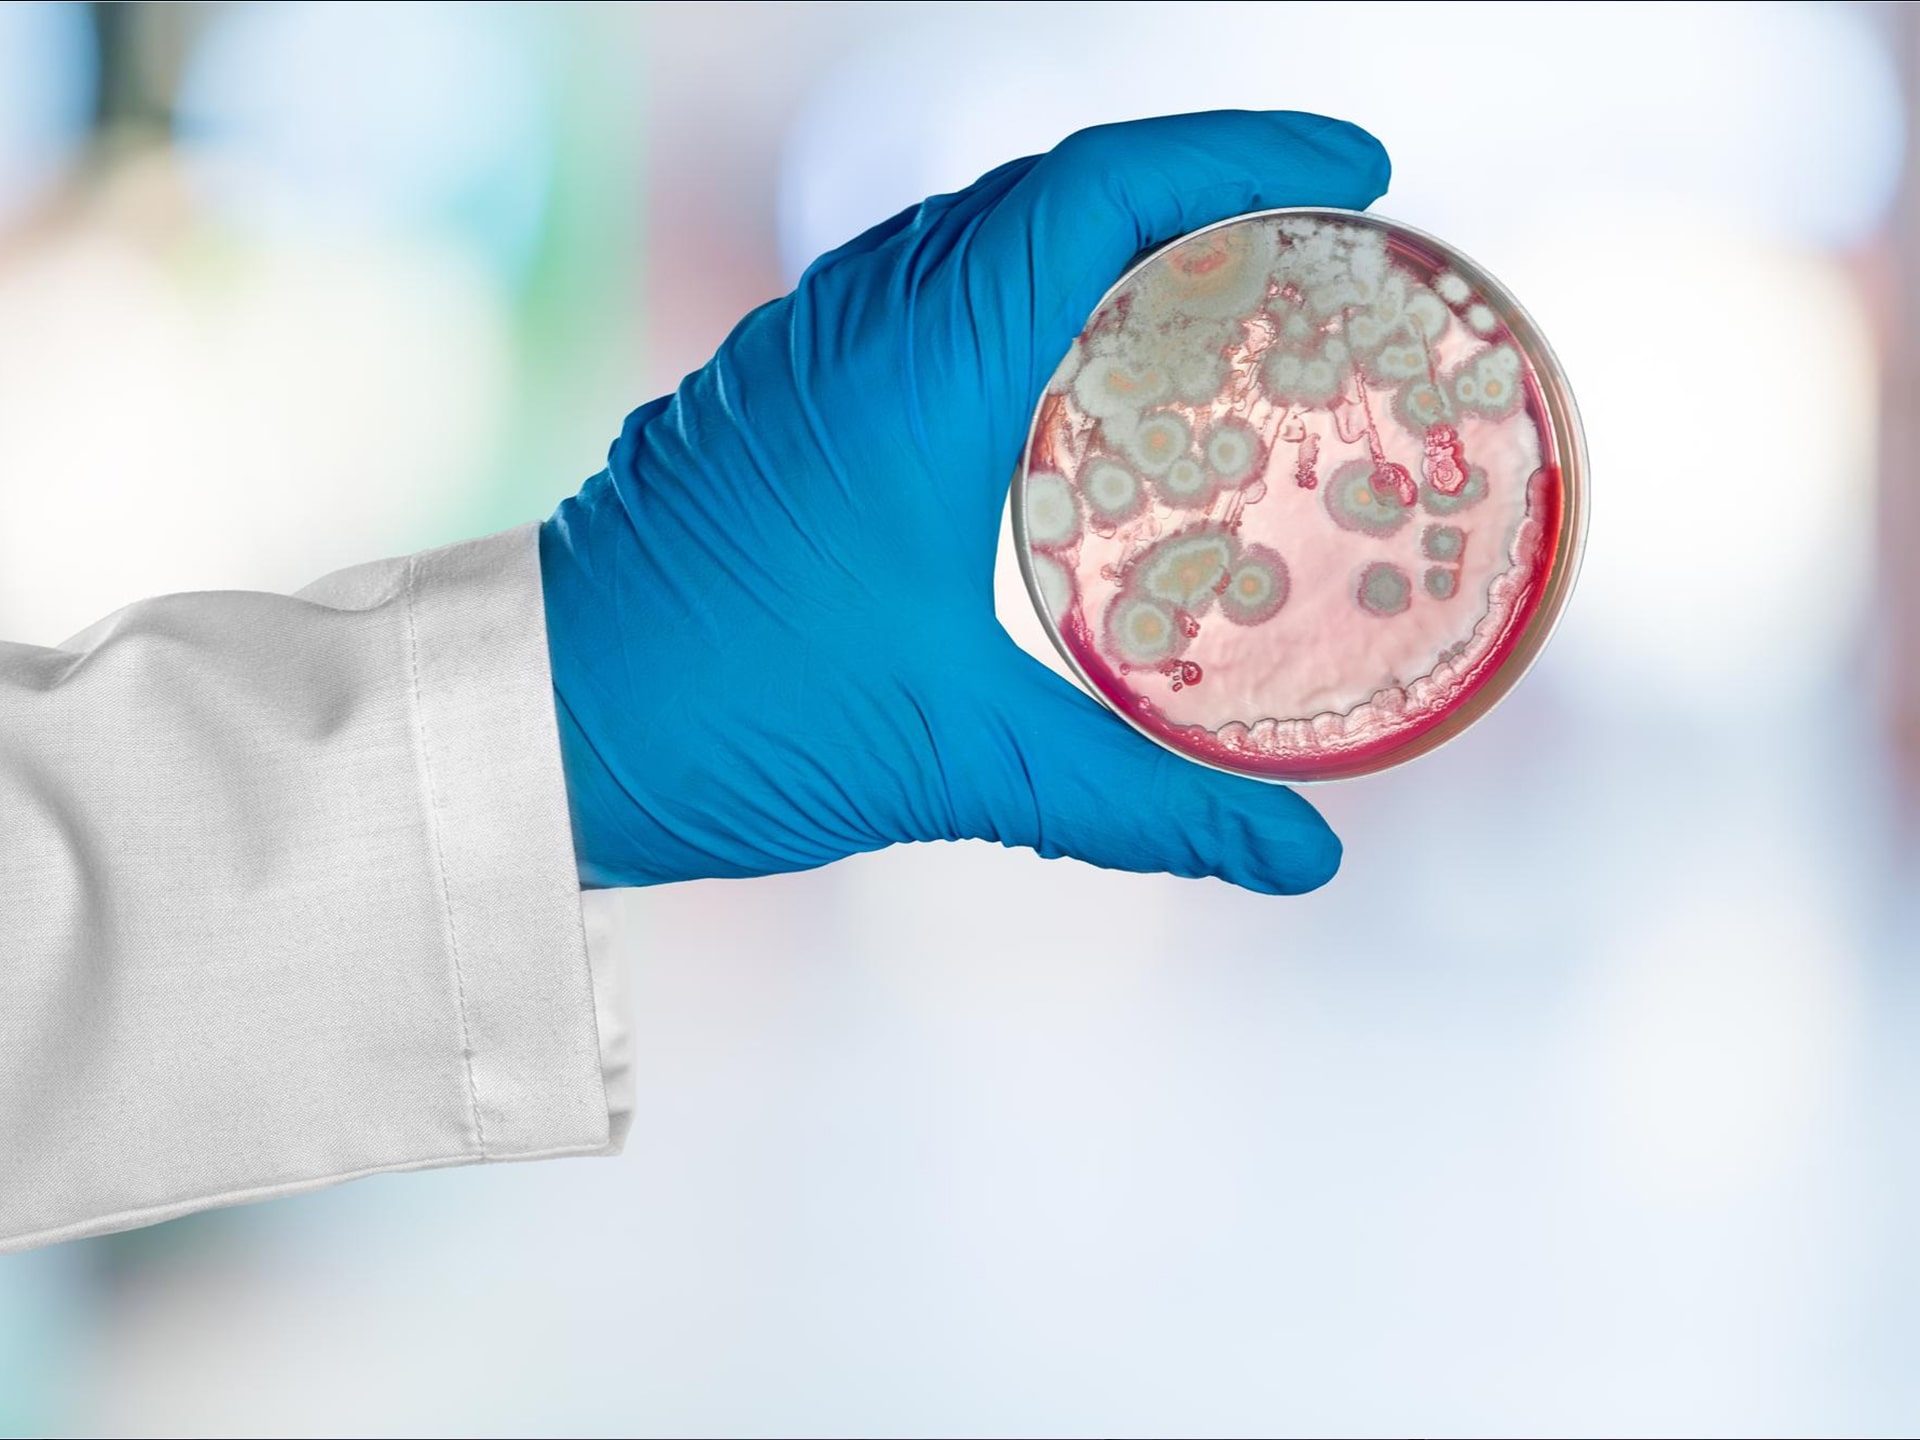
OneGI

Improve patient access, staff efficiency,
and security.
We align teams, connect systems, and create clear experiences so patients get care faster and your staff gets time back.
Sound familiar?
Tight margins, strict rules, and legacy tools make care journeys harder than they should be.
Access friction
Services, insurance, and next steps are unclear, so phones clog and patients drop.Tool sprawl
EHR, scheduling, billing, and CRM do not sync, which causes retyping and errors.Security and compliance
HIPAA risk and ransomware worries slow projects and approvals.Staffing strain
Short teams and heavy admin work fuel burnout and delays.Here is how we help
Reduce friction, protect data, and make reporting simple.


Don’t just take our word for it - here’s what our clients say about us!
Real stories, real impact
Outcomes like fewer no-shows, faster scheduling, lower call volumes, and stronger security.
Why teams choose us
You get a partner who understands budgets, communicates clearly, aligns to campaign calendars, and supports your staff well after go live.

Ready to modernize patient access and operations?
Let’s connect systems, protect data, and shorten the path from search to scheduled visit.

Frequently Asked Questions
Quick answers on EHRs, HIPAA, scheduling, and security.